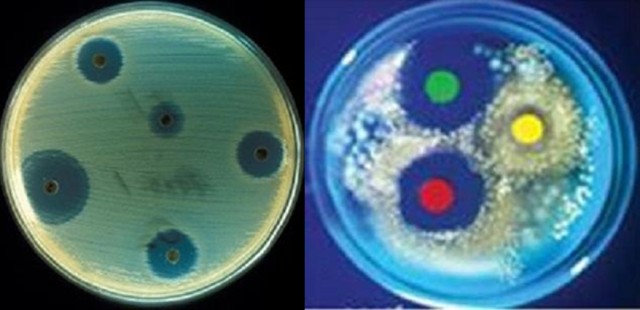
vi khuẩn Staphylococcus aureus

Kiểm tra tính nhạy của vi khuẩn Staphylococcus aureus với kháng sinh theo phương pháp đĩa khuếch tán kháng sinh của Kirby-Bauer: Kháng sinh trong đĩa thạch ức chế sự phát triển của S. Aureus (trái); Kháng sinh đồ trên đĩa thạch (phải)
Một số lưu ý khi sử dụng thuốc trị bệnh ở thủy sản nuôi
Vi khuẩn gây bệnh ở cá chủ yếu là vi khuẩn gram âm, thường gặp là Edwardsiella ictaluri, Speudomonas spp, Aeromonas spp, Flexibacter columnaris… Các vi khuẩn này đều chịu tác động của kháng sinh khi điều trị.
1. Chọn kháng sinh
- Vi khuẩn gây bệnh ở cá chủ yếu là vi khuẩn gram âm, thường gặp là Edwardsiella ictaluri, Speudomonas spp, Aeromonas spp, Flexibacter columnaris… Các vi khuẩn này đều chịu tác động của kháng sinh khi điều trị. Tuy nhiên, tại một số nơi vi khuẩn có tỷ lệ đề kháng cao với một số loại kháng sinh như florphenicol, oxytetracycline, phối hợp sulfamethoxazol + trimethoprim,... Do đó, để việc điều trị có hiệu quả cần lấy mẫu cá bệnh làm kháng sinh đồ, chọn loại thuốc còn nhạy với mầm bệnh điều trị bệnh cho cá (không sử dụng kháng sinh đã bị vi khuẩn kháng lại vì những kháng sinh này không còn tác dụng đối với vi khuẩn kháng thuốc).
- Đối với cá nuôi thương phẩm, việc đưa thuốc điều trị bệnh vào cơ thể thông qua trộn thuốc vào thức ăn là giải pháp tốt nhất. Tuy nhiên, do một số kháng sinh không hấp thu hoặc hấp thu kém qua niêm mạc ruột nên chỉ tạo được tác dụng diệt khuẩn cục bộ, còn khi vi khuẩn xâm nhập vào máu, tác động đến mô, phá huỷ tổ chức cơ thể thì hiệu quả điều trị của kháng sinh sẽ không cao. Các kháng sinh có đặc tính này điển hình là colistin và hầu hết kháng sinh nhóm aminoglycosid (streptomycin, kanamycin, gentamycin…).
- Đối với thức ăn tự chế biến, người nuôi thủy sản có thể đưa thuốc vào trong quá trình nhào trộn thức ăn. Tuy nhiên, khi sử dụng thức ăn công nghiệp (dạng viên với cỡ khác nhau) thì cần chọn thuốc hoà tan tốt trong nước để có thể tưới tẩm thuốc đồng đều vào từng viên thức ăn. Do đó, một số thuốc không hoà tan như florphenicol, trimethoprim hay hoà tan kém như kháng sinh nhóm fluroquynolones (nếu là thủy sản nuôi để xuất khẩu vào thị trường Mỹ và Bắc Mỹ thì không được sử dụng nhóm kháng sinh này), sulfamides... sẽ không ngấm sâu được vào viên thức ăn, lớp bột thuốc bám lỏng lẻo bên ngoài viên thức ăn sẽ nhanh chóng bị rửa trôi khi vào môi trường nước ao nuôi, hậu quả là cá bệnh không được cấp đủ liều thuốc điều trị.
- Nhiều loại kháng sinh bị giảm tác dụng do gắn kết với các thành phần có trong thức ăn hay có trong nước dùng pha thuốc (nhóm tetracycline, fluoroquynolones) hoặc bị phân huỷ bởi axít dịch vị khi ở lâu trong dạ dày (penicillin, ampicillin, amoxycillin,…), do đó nên kiểm tra nước dùng pha thuốc. Nước cứng quá hoặc có chứa nhiều ion kim loại không phù hợp để pha các kháng này.
2. Chọn thuốc hỗ trợ
Thuốc hỗ trợ không phù hợp sẽ gây lãng phí làm tăng giá thành điều trị. Cần chú ý một số điểm sau:
- Nên dùng thuốc làm tăng khả năng đề kháng như beta-glucan, vitamin C, vi sinh vật hữu ích (Bacillus subtilis, Lactobacillus axítophilus, Saccharomyces cerevisiae…) bổ sung vào thức ăn cho cá trong giai đoạn cá khỏe để phòng bệnh. Cần chú ý khi sử dụng probiotic thì không kết hợp cùng lúc với kháng sinh vì kháng sinh sẽ diệt luôn vi khuẩn hữu ích được bổ sung vào thức ăn.
- Các thuốc dùng trong giai đoạn bệnh để hỗ trợ điều trị là vitamin C, B complex và các enzyme tiêu hoá, đặc biệt là protease cần cung cấp đủ nhu cầu của cá (theo hướng dẫn của nhà sản xuất) vì khi bị bệnh, cá tiêu hoá rất kém, nếu không bổ sung men tiêu hóa thì cá ăn càng nhiều tỷ lệ chết càng gia tăng do rối loạn tiêu hoá và nhiễm khuẩn đường ruột (Protease là tên chung của nhóm enzyme có khả năng thủy phân các liên kết peptid của chuỗi peptid, protein thành các đoạn peptid ngắn hơn và các acid amin. Có thể hiểu đơn giản: protease là enzyme xúc tác cho việc tiêu hóa protein).
- Thuốc có chất chống ôxy hoá mạnh như vitamin A, E, selenium dùng rất tốt sau giai đoạn bệnh để giúp cá hồi phục sức khỏe, cải thiện chất lượng thịt do tác động giải độc, trung hoà các gốc tự do hình thành trong thời kỳ bệnh.
Nguồn: Khuyến nông VN, 31/12/2013


_1773203218.png)


